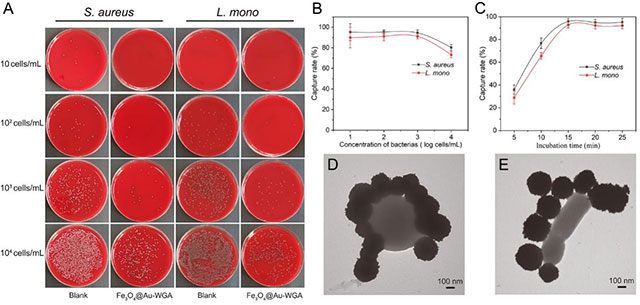
20220221-13.jpg

关注我们


2022年1月3日,广东省人民医院检验科顾兵教授团队在分析化学领域国际一流期刊《Analytica Chimica Acta》发表了题为“An efficient SERS platform for the ultrasensitive detection of Staphylococcus aureus and Listeria monocytogenes via wheat germ agglutinin-modified magnetic SERS substrate and streptavidin/aptamer co-functionalized SERS tags”的文章(doi:10.1016/j.aca.2021.339155)。该文章首次提出了基于麦胚凝集素修饰的磁性SERS光谱对两种病原菌同时快速检测的新方法。
麦胚凝集素通过氢键与细菌表面N-乙酰葡萄糖胺及其衍生物的特异性结合,可实现病原菌的高效广谱捕获。基于链霉亲和素生物素系统修饰的SERS标签增加了AuNP表面上的适配体结合效率并提高SERS标签在高盐溶液中的稳定性。该传感器以金黄色葡萄球菌和产单核李斯特菌在为例,可以在10-107cells/mL范围内,实现定量检测,灵敏度可达 3 cfu/mL和 5 cfu/mL。

图1 麦胚凝集素金壳磁珠(A)和SERS标签的合成(B),以及该生物传感器对两种病原体同时检测原理(C)

图2 成功制备麦胚凝集素修饰的金壳磁珠和两种特异性SERS标签
图3 麦胚凝集素金壳磁珠对两种目标细菌具有高效的捕获效率(> 90%)和较短的捕获时间(< 15 min)

图4基于链霉亲和素生物素系统修饰的SERS 标签有着更强的结合能力

图5 10-107 cells/mL病原体浓度对数和 SERS 强度之间呈吻合线性关系

图6具有多重检测能力和良好的重复性
课题组还通过几种真实的食物样本(果汁、莴苣提取物)和人类尿液对该平台的潜在应用进行了评估。这项工作首次使用基于麦胚凝集素修饰的磁性SERS光谱,同时对金黄色葡萄球菌和单核葡萄球菌进行快速识别鉴定。通过改变特定的适配子,该方法还具有很强的应用潜力,可以作为一种灵敏和通用的检测工具,用于其他病原体的多重检测。
邓倩昀